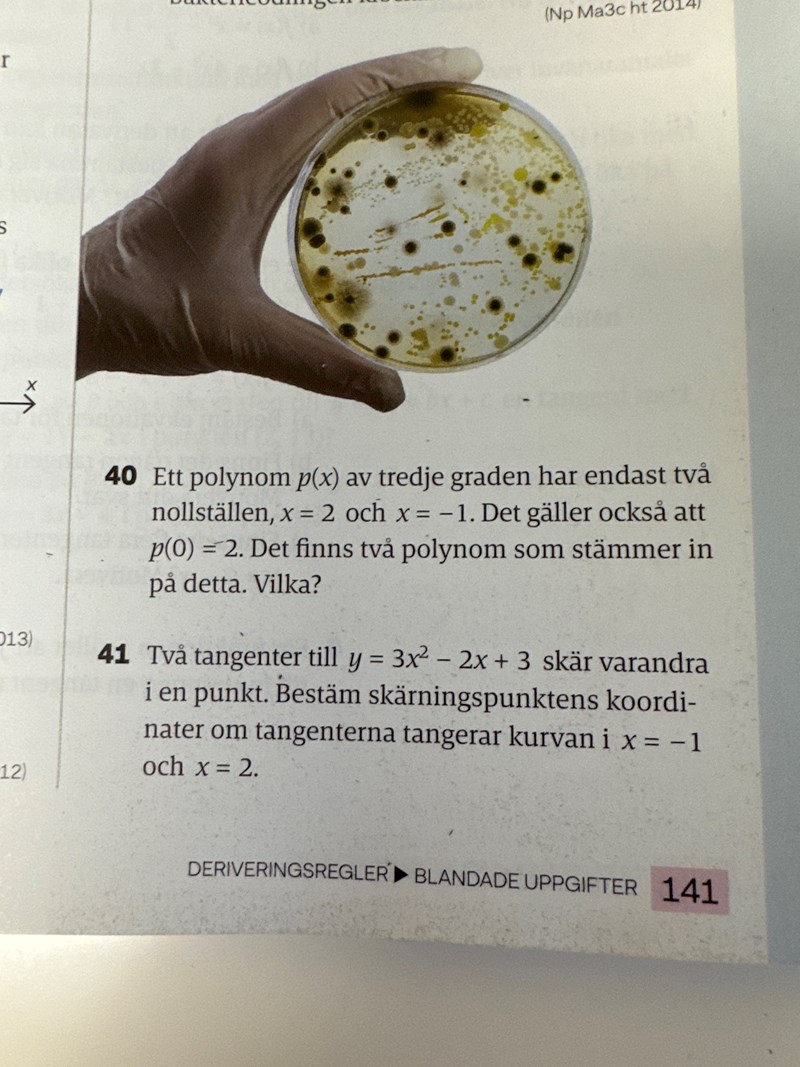

Tredjegrads polynom
Uppgift 40. Jag kollade i facit och förstod att antingen x^2 finns inte i polynomet eller x. Men tar mig inte längre än så.
yabi_G skrev:Uppgift 40. Jag kollade i facit och förstod att antingen x^2 finns inte i polynomet eller x. Men tar mig inte längre än så.
En möjlighet är y=(x-2)2(x+1)/2
tack, med det stod i facit. Jag visste inte hur man skulle göra.
yabi_G skrev:tack, med det stod i facit. Jag visste inte hur man skulle göra.
Men nu ser du hur du hittar den andra möjligheten?
jo det gick. Men vad skulle jag göra för att hitta det första polynomet?
yabi_G skrev:jo det gick. Men vad skulle jag göra för att hitta det första polynomet?
Om x1 är ett nollställe är (x - x1) en faktor av polynomen. Här var två nollställen givna och det sades att det var de enda två, så jag tänkte att antingen det ena eller det andra måste vara ett dubbelt nollställe, och det ger ju två olika polynomer: (x - x1)2 ·(x - x2) och (x - x1)·(x - x2)2
Sedan en faktor för vardera för att få värdet vid x=0 för dessa båda.
tack!
